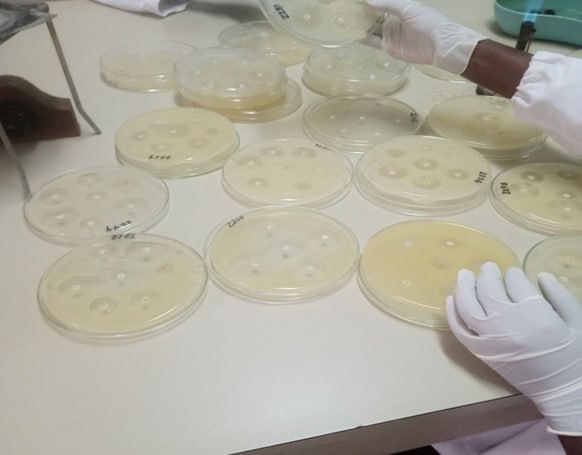
Bacteriology

Latest News
View All NewsServices
View All Services

About Us
Learn More About Us
About Bedele Regional Veterinary Laboratory Center
Bedele Regional Veterinary Laboratory Center (BRVLC) was established in 1973 E.C...
Read MoreResources
View All ResourcesResearch & Development
View All ResearchContact Us
our_offices
Bedele Regional Veterinary Laboratory
Metu street, Bedele, Ethiopia POB. 15 Bedele, Ethiopia
0474450169/04744017
brvlc2019@gmail.com

